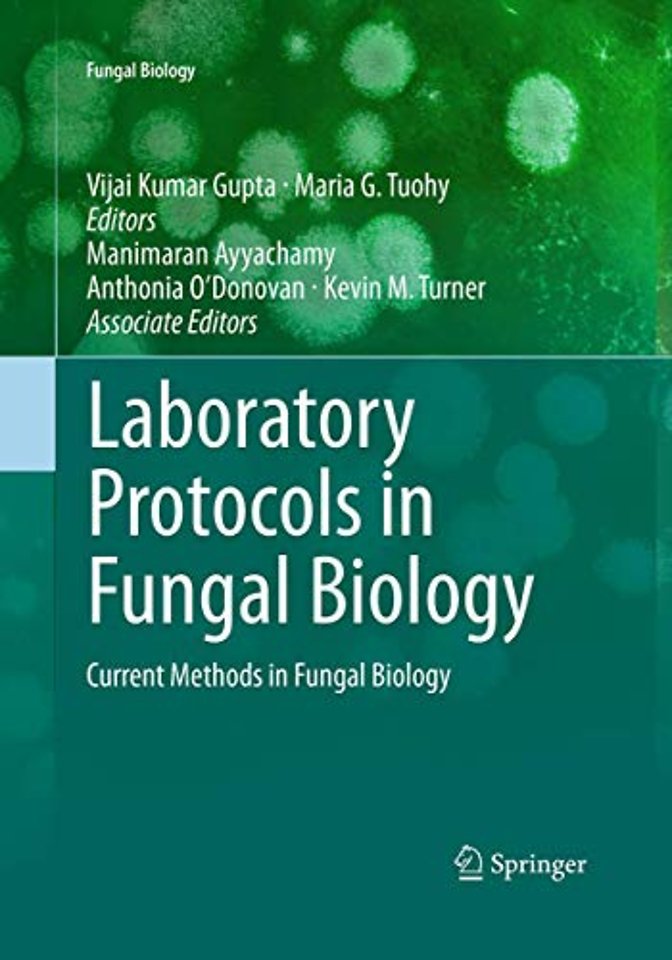
Laboratory Protocols in Fungal Biology

<p>1. Safety Norms and Regulations in Handling Fungal Specimens</p><p>Finola E. Cliffe </p><p> </p>2. Methods of Cryopreservation in Fungi<p>Ladislav Homolka</p><p> </p><p>3. Long Term Preservation of Fungal Cultures in All-Russian Collection of Microorganisms (VKM): Protocols and Results</p><p>Svetlana M. Ozerskaya, Natalya E. Ivanushkina, Galina A. Kochkina, Svetlana S. Eremina, Alexander N. Vasilenko, and Nadezhda I. Chigineva</p><p> </p><p>4. Fungal Specimen Collection and Processing.</p><p>Anthonia O’Donovan, Vijai Kumar Gupta, and Maria G. Tuohy</p><p> </p><p>5. Chemical and Molecular Methods for Detection of Toxigenic Fungi and Their Mycotoxins from Major Food Crops</p><p>S. Chandra Nayaka, A.C. Udayashankar, M.Venkata Ramana, S.R. Niranjana, C. N. Mortensen, and H.S. Prakash</p><p> </p>6. Identification Key for the Major Growth Forms of Lichenized Fungi<p><p>Jayabalan Sangeetha and Devarajan Thangadurai</p><p> </p><p>7. Microscopic Methods for Analytical Studies of Fungi</p><p>De-Wei Li</p><p> </p><p>8. Scanning Electron Microscopy for Fungal Sample Examination</p><p>Eduardo Alves, Gilvaine Ciavareli Lucas, Edson Ampélio Pozza, and Marcelo de Carvalho Alves</p><p> </p><p>9. High Resolution Imaging and Force Spectroscopy of Fungal Hyphal Cells by Atomic Force Microscopy</p><p>Tanya Dahms</p><p> </p><p>10. Use of Fourier-Transform Infrared (FTIR) Microscopy Method For Detection of Phyto-Fungal Pathogens</p><p> Vitaly Erukhimovitch and Mahmoud Huleihel</p><p> </p><p>11. Diagnose of Parasitic Fungi in The Plankton: Technique for Identifying And Counting Infective Chytrids Using Epifluorescence Microscopy</p><p>Télesphore Sime-Ngando, Serena Rasconi, and Mélanie Gerphagnon</p><p> </p><p>12. Fungal Cell Wall Analysis</p><p> Pilar Pérez and Juan C. Ribas</p><p> </p><p>13. Histopathological Technique for Detection of Fungal Infections in Plants</p><p>Vijai Kumar Gupta and Brejesh Kumar Pandey </p><p> </p><p>14. Development of Media for Growth and Enumeration of Fungi from Water</p><p>Segula Masaphy</p><p> </p><p>15. Sabouraud Agar for Fungal Growth</p><p>Janelle M. Hare</p><p> </p><p>16. A Method for the Formation of Candida Biofilms in 96 Well Microtiter Plates and its Application to Antifungal Susceptibility Testing</p><p>Christopher G. Pierce, Priya Uppuluri, and Jose L. Lopez-Ribot</p><p> </p><p>17. Screening for Compounds Exerting Antifungal Activities</p><p>Jean-Paul Ouedraogo, Ellen L. Lagendijk, Cees A.M.J.J van den Hondel, Arthur F.J. Ram, and Vera Meyer</p><p> </p><p>18. Fluorescence In situ Hybridization of Uncultured Zoosporic Fungi</p><p>Télesphore Sime-Ngando, Marlène Jobard, and Serena Rasconi</p><p> </p><p>19. Staining Techniques and Biochemical Methods for the Identification of Fungi </p><p>Jayabalan Sangeetha and Devarajan Thangadurai</p><p> </p><p>20. Protocol for the In vivo Quantification of Superoxide Radical in Fungi </p><p>Grintzalis Konstantinos, Papapostolou Ioannis, and Christos Georgiou</p><p> </p><p>21. Isolation of Intact RNA from Sorted S. cerevisiae Cells for Differential Gene Expression Analysis</p><p>Jeannette Vogt, Frank Stahl, Thomas Scheper, and Susann Müller</p><p> </p><p>22. Quantitative PCR Analysis of Double-Stranded RNA-Mediated Gene Silencing in Fungi</p><p>José Javiar de Vega-Bartol, María Vega Tello Hernández, Jonathan Niño Sánchez, Virginia Casado del Castillo, and José M. Díaz-Mínguez</p><p> </p><p>23. Semi-nested PCR Approach to Amplify Large 8S rRNA Gene Fragments for PCR-DGGE Analysis of Soil Fungal Communities</p><p>Miruna Oros-Sichler and Kornelia Smalla</p><p> </p><p>24. Proteomic Protocols for the Study of Filamentous Fungi</p><p>Raquel González Fernández and Jesús V. Jorrín Novo</p><p> </p><p>25. Detection and Quantification of Endoprotease Activity Using a Coomassie Dye-Binding Assay</p><p>Anthony J. O’Donoghue and Cathal S. Mahon</p><p> </p><p>26. Protocol of a LightCyclerÔ PCR Assay for Detection and Quantification of Aspergillus fumigatus DNA in Clinical Samples of Neutropenic Patients</p><p> Birgit Spiess and Dieter Buchheidt</p><p> </p><p>27. Application of Polymerase Chain Reaction (PCR) and PCR Based Methods Targeting Internal Transcribed Spacer (ITS) for Detection and Species Level Identification of Fungi</p><p>K. Lily Therese, R. Bagyalakshmi, and H. N. Madhavan </p><p> </p><p>28. Real-Time PCR Assay in Fungi</p><p>Naomichi Yamamoto</p><p> </p><p>29. Quantitative Sampling Methods for the Analysis of Fungi: Air Sampling</p><p>Mary C. O’Loughlin, Katherine D. Turner, and Kevin M. Turner </p><p> </p><p>30. Transformation of Filamentous Fungi in Microtiter Plate</p><p>Bianca Gielesen and Marco van den Berg</p><p> </p><p>31. Molecular Fingerprinting of Fungal Communities in Soil</p><p>Roberto A. Geremia and Lucie Zinger</p><p> </p><p>32. Development of Microsatellite Markers from Fungal DNA Based on Shotgun Pyrosequencing</p><p>Shaobin Zhong</p><p> </p><p>33. Multiplex and Quantifiable Detection of Infectious Fungi Using Padlock Probes, General qPCR and Suspension Microarray Readout</p><p>Magnus Jobs, Ronnie Eriksson, and Jonas Blomberg</p><p> </p><p>34. Rapid Deletion Plasmid Construction Methods for Protoplast and Agrobacterium-based Fungal Transformation Systems</p><p>María D. García-Pedrajas, Zahi Paz, David L. Andrews, Lourdes Baeza-Montañez, and Scott E. Gold</p><p> </p><p>35. Improved Transformation Method for Alternaria brassicicola and its Applications</p><p>Yangrae Cho, Akhil Srivastava, and Christopher Nguyen</p><p> </p><p>36. Methods for High Quality DNA Extraction from Fungi</p><p> Vijai Kumar Gupta, Maria G. Tuohy and Rajeeva Gaur</p><p> </p><p>37. Production of Recombinant Proteins from Pichia pastoris: Interfacing Fermentation and Immobilized Metal Ion Affinity Chromatography</p><p>Berend Tolner, Gaurav Bhavsar, Bride Foster, Kim Vigor, and Kerry Chester</p> <p>38. Development of a Real-Time Quantitative PCR Assay for the Assessment of Uncultured Zoosporic Fungi</p><p>Télesphore Sime-Ngando and Marlène Jobard </p><p> </p><p>39. Nucleic and Protein Extraction Methods for Fungal Exopolysaccharide Producers</p><p>Jochen Schmid, Dirk Mueller-Hagen, Volker Sieber, and Vera Meyer</p><p> </p><p>40. Directed Evolution of A Fungal Xylanase for Improvement of Thermal and Alkaline Stability</p><p> Dawn Elizabeth Stephens, Suren Singh, and Kugen Permaul</p><p> </p><p>41. Genome Shuffling Protocol for the Pentose-Fermenting Yeast Scheffersomyces stipitis</p><p>Paramjit K. Bajwa, Nicole K. Harner, Terri L. Richardson, Sukhdeep Sidhu, Marc B. Habash, Jack T. Trevors, and Hung Lee</p> 42. Detection and Identification of Fungal Microbial Volatile Organic Compounds by HS-SPME-GC-MS<p>Bernhard Kluger, Susanne Zeilinger, Gerlinde Wiesenberger, Denise Schöfbeck, and Rainer Schuhmacher</p><p> </p>43. Transformation Methods for Slow Growing Fungi<p> Suman Mukherjee and Rebecca Creamer</p><p> </p><p>44. Enzymatic Saccharification of lignocellulosic biomass</p><p>Manimaran Ayyachamy, Vijai Kumar Gupta, Finola E. Cliffe, and Maria G. Tuohy</p><p> </p><p>45. Protoplast Fusion Techniques in Fungi</p><p>Annie Juliet Gnanam </p><p> </p><p>46. Large Scale Production of Lignocellulolytic Enzymes in Thermophilic Fungi</p><p>Manimaran Ayyachamy, Mary Shier, and Maria G. Tuohy</p><p> </p><p>47. Panfungal PCR Method for Detection of Aflatoxigenic Molds</p><p>Malik M. Ahmad, Pravej Alam, M. Z. Abdin, and Saleem Javed</p><p> </p><p>48. Protocols for the Quantification of dsDNA and Its Fragmentation Status in Fungi</p><p>Ioannis Papapostolou, Konstantinos Grintzalis, and Christos Georgiou</p><p> </p><p>49. Rapid Identification and Detection of Pathogenic Fungi by Padlock Probes</p><p>Clement K. M. Tsui, Bin Wang, Cor D. Schoen, and Richard C. Hamelin</p><p> </p><p>50. Drug-Induced Permeabilization in Fungi</p><p>Maria D. Mayan, Alexandra MacAleenan, and Priscilla Braglia</p><p> </p><p>51. Extraction and Characterization of Taxol: An Anticancer Drug from an Endophytic And Pathogenic Fungi</p><p>M. Pandi P. Rajapriya and P. T. Manoharan</p><p> </p><p>52. Identification of Mycotoxigenic Fungi using an Oligonucleotide Microarray</p><p>Eugenia Barros</p><p> </p><p>53. DNA Microarray-Based Detection and Identification of Fungal Specimens</p><p>Minna Mäki</p><p> </p>54. Bioinformatic Protocols and the Knowledge-Base for Secretomes in Fungi<p><p>Gengkon Lum and Xiang Jia Min</p><p> </p><p>55. High-Throughput Functional Annotation and Data Mining of Fungal Genomes to Identify Therapeutic Targets</p><p>Gagan Garg and Shoba Ranganathan</p><p> </p><p>56. Application of Support Vector Machines in Fungal Genome and Proteome Annotation</p><p>Sonal Modak, Shimantika Sharma, Prashant Prabhakar, Akshay Yadav, and V. K. Jayaraman</p><p> </p><p>57. Bioinformatics Tools for the Multilocus Phylogenetic Analysis of Fungi</p><p>Devarajan Thangadurai and Jayabalan Sangeetha </p><p>